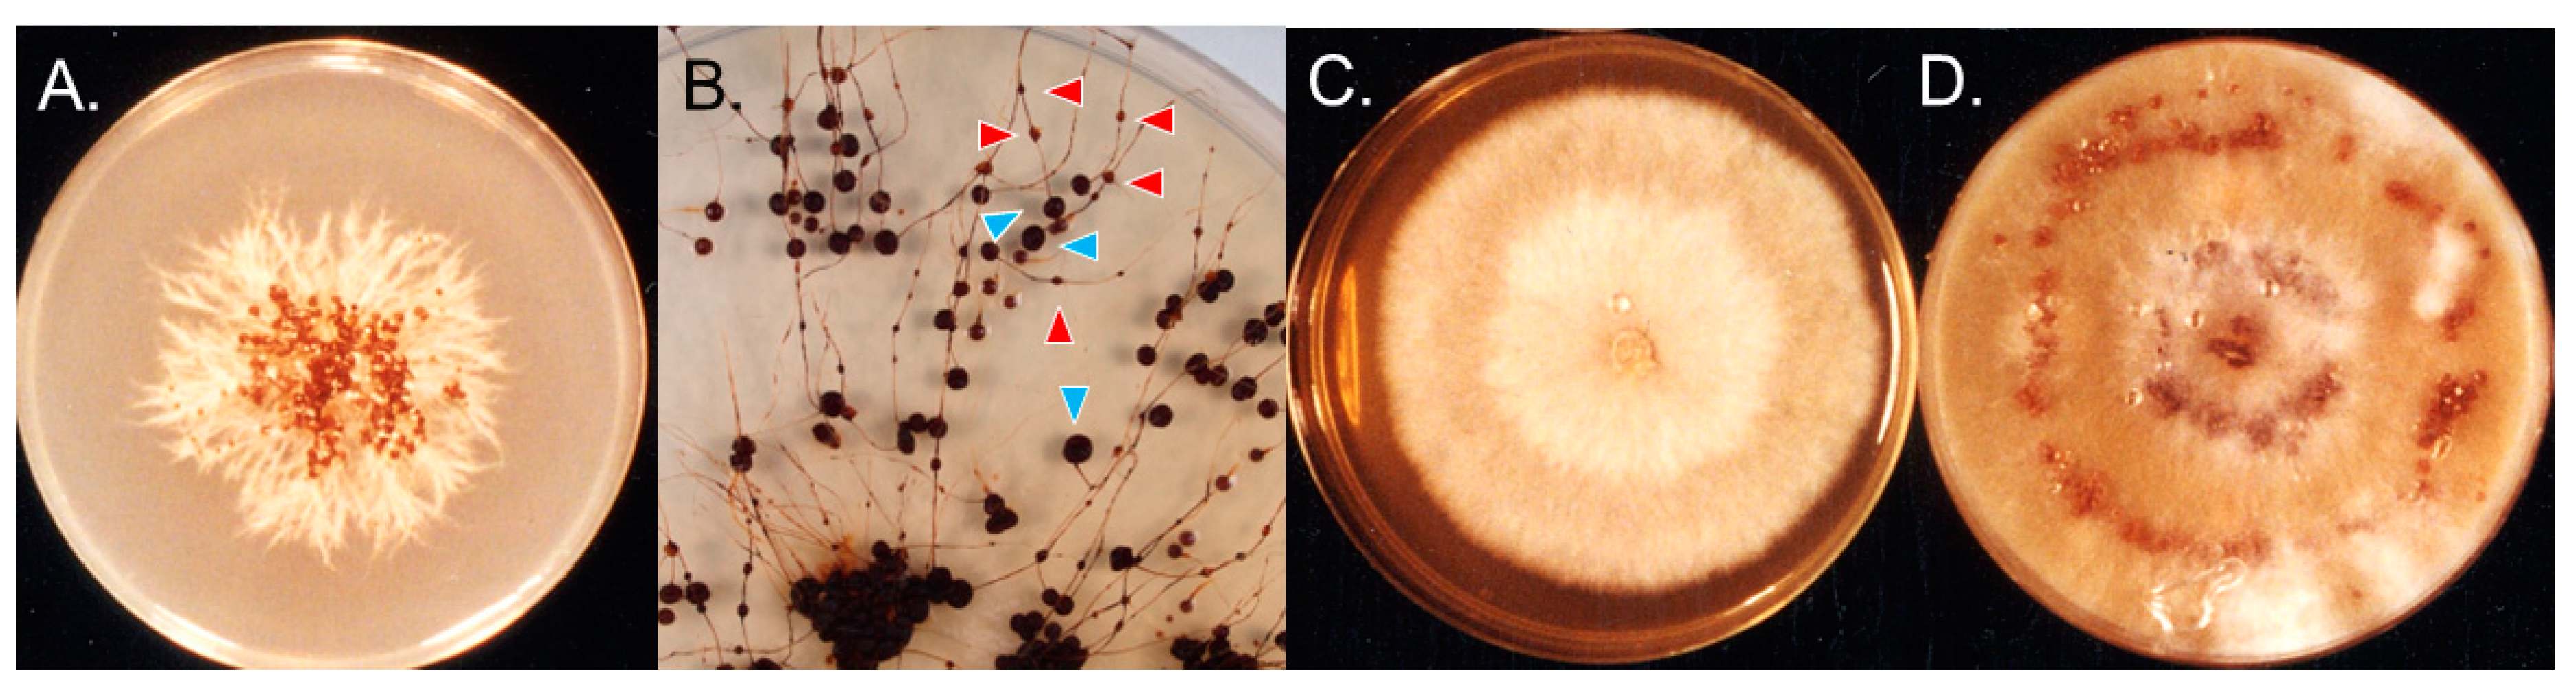
Preprints 77875 g002

Submitted:
27 June 2023
Posted:
28 June 2023
You are already at the latest version
Abstract

Keywords:
1. Introduction
2. Materials and Methods
2.1. Fungal materials
2.2. Mating experiments
2.3. Phylogenic analyses
2.4. Morphological observations
2.5. Mycelial growth temperature
3. Results
3.1. Typhula hyperborea in Greenland
3.2. Typhula sp. and Pistillaria petasitis in Hokkaido, Japan
3.3. Effect of temperature on mycelial growth
4. Discussion
Author Contributions
Funding
Data Availability Statement
Acknowledgments
Conflicts of Interest
References
- Gounot, A.M. Microbial life in permanently cold soils. In Cold-adapted organisms: Ecology, physiology, enzymology and molecular biology; Springer: Berlin, Germany, 1999; pp. 3–16. [Google Scholar]
- Dobrowolski, A.B. Historia naturalna lodu, Kasa Pomocy im. Dr J. Mianowskiego, Warsaw, Poland, 1923.
- Barry, R.; Jania, J.; Birkenmajer, K.A.B. Dobrowolski – the first cryospheric scientist – and the subsequent development of cryospheric science. Hist. Geo. Space Sci. 2011, 2, 75–79. [Google Scholar] [CrossRef]
- Barry, R.; Gan, T.Y. The Global Cryosphere Past, Present and Future; Cambridge University Press: Cambridge, UK, 2011. [Google Scholar]
- Friedmann, I. Antarctic Microbiology; Wiley-Liss: New York, NY, USA, 1993. [Google Scholar]
- Frisvad, J.C. Fungi in cold ecosystems. In Psycrophiles: from Biodiversity to Biotechnology; Springer: Berlin, Germany, 2008; pp. 137–156. [Google Scholar]
- Ozerskaya, S.; Kochkina, G.; Ivanushkina, N.; Gilichinsky, D.A. Fungi in Permafrost. In Permafrost Soils; Springer: Berlin, Germany, 2009; pp. 85–95. [Google Scholar]
- Tojo, M.; Newsham, K.K. Snow moulds in polar environments. Fungal Ecol. 2012, 5, 395–402. [Google Scholar] [CrossRef]
- Matsumoto, N.; Hsiang, T. Snow mold. The battle under snow between fungal pathogens and their plant hosts; Springer: Singapore, 2016. [Google Scholar]
- Kirk, P.M.; Cannon, P.F.; Minter, D.W.; Stalpers, J.A. Ainsworth & Bisby’s Dictionary of Fungi; CAB International: Wallingford, UK, 2008. [Google Scholar]
- Cavalier-Smith, T. A revised six-kingdom system of life. Biol. Rev. 1998, 73, 203–266. [Google Scholar] [CrossRef]
- Hoshino, T.; Matsumoto, N. Cryophilic fungi to denote fungi in the cryosphere. Fungal Biol. Rev. 2012, 26, 102–105. [Google Scholar] [CrossRef]
- Hoshino, T.; Matsumoto, N. Environmental influence the psychrophily of fungi and oomycetes in the cryosphere. Karstenia 2013, 53, 49–54. [Google Scholar] [CrossRef]
- Jamalainen, E.A. Overwintering of Gramineae-plants and parasitic fungi. I. Sclerotinia borealis, Bubak & Vleugel. J. Sci. Agric. Soc. Finl. 1949, 21, 125–142. [Google Scholar]
- Jamalainen, E.A. Overwintering of Gramineae-plants and parasitic fungi. II. On the Typhula sp-.fungi in Finland. J. Sci. Agric. Soc. Fin. 1957, 29, 75–81. [Google Scholar] [CrossRef]
- Lebeau, J.B.; Longsdon, C.E. Snow mold of forage crops in Alaska and Yukon. Phytopathology 1958, 48, 148–150. [Google Scholar]
- Årsvoll, K. Effects of hardening, plant age, and development in Phleum pratense and Festuca pratensis on resistance to snow mould fungi. Meld. Nor. Landbrukshøgsk. 1977, 56, 1–14. [Google Scholar]
- Khokhryakova, T.M. Typhula blight and sclerotinia rot affection of graces on the north and north-west of nonchernozem zone of the RSFR (in Russian, with English abstract). Bull. Appl. Bot. Genet. Plant Breed. 1983, 82, 45–51. [Google Scholar]
- Hoshino, T.; Saito, I.; Tronsmo, A.M. Two snow mold fungi from Svalbard. Lidia 2003, 6, 30–32. [Google Scholar]
- Shiryaev, A.G. Clavarioid fungi of Urals. I. Boreal forest zone. Mikol. Fitopatol. 2004, 38, 59–72. [Google Scholar]
- Hoshino, T.; Saito, I.; Yumoto, I. New findings of snow mold fungi from Greenland. Medd. on Grønl. Biosci. 2006, 56, 89–94. [Google Scholar]
- Shiryaev, A.G. Clavarioid fungi of Urals. III. Arctic Zone (in Russian, with English abstract). Mikol. Fitopatol. 2006, 40, 294–306. [Google Scholar]
- Shiryaev, A.G. Clavarioid fungi of the tundra and forest-tundra zones of Kola Peninsula (Murmansk region) (in Russian, with English abstract). Novsti. Syst. Vyssh. Rast. 2009, 43, 134–149. [Google Scholar]
- Shiryaev, A.G.; Mukhin, V.A. Clavariod-type fungi from Svalbard: their spatial distribution in the European High Arctic. North Am. Fungi 2010, 5, 68–84. [Google Scholar]
- Shiryaev, A.G. Geographical specificy of the tundra and boreal biota of clavarioid fungi in Chukotka (in Russian, with English abstract). Bull. Moscow Stat. Nat. Biol. Ser. 2013, 118, 67–79. [Google Scholar]
- Shiryaev, A.G. Spatial heterogeneity of the species composition of Clavarioid fungi’s complex in the Eurasian Arctic. Contemp. Probl. Ecol. 2013, 6, 381–389. [Google Scholar] [CrossRef]
- Hoshino, T.; Nakagawa, T.; Yajima, Y.; Uchida, M.; Tojo, M. Note on a snow mold and fungus-like microbe from Kuujjuarapik-Whapmagoostui, Quebec, subarctic Canada. Polar Sci. 2021, 27, 100559. [Google Scholar] [CrossRef]
- Hoshino, T.; Tkachenko, O.B.; Tojo, M.; Tronsmo, A.M.; Kasuya, T.; Matsumoto, N. Taxonomic revisionof the Typhula ishikariensis complex. Mycoscience 2022, 63, 118–130. [Google Scholar] [CrossRef]
- Gamundi, I.J.; Spideni, H.A. Sclerotinia antarctica sp. nov., the teleomorph of the first fungus described from Antarctica. Mycotaxon 1987, 29, 81–89. [Google Scholar]
- Yajima, Y.; Tojo, M.; Chen, B.; Hoshino, T. Typhula cf. subvariabilis, new snow mold in Antarctica. Mycology 2017, 8, 147–152. [Google Scholar] [PubMed]
- Christen, A.A. Interspecific matting relationships between Typhula ishikariensis and Typhula idahoesnsis. Ph.D. thesis, Washington State University, Pullman, WA, USA, 1978. [Google Scholar]
- Christen, A.A. Formation of secondary sclerotia in sporophores of species of Typhula. Phytopathology 1979, 71, 1267–1269. [Google Scholar] [CrossRef]
- Jülich, W. Higher taxa of Basidiomycetes. Bibl. Mycol. 1982, 85, 1–485. [Google Scholar]
- Fris, E.M. Observationes mycologicae vol 2; Havniae, sumptibus G. Bonnieri, 1815. [Google Scholar]
- Karstin, P.A. Rysslands, Finlands och den Skandinaviska halföns Hattsvampar, Sednare delen: Pip-, Tagg-, Klubb- och Gelesvampar.P.A. Bidr. Kann. Finl. Nat. Folk. 1882, 37, 1–257. [Google Scholar]
- Corner, E.J.H. Supplement to a monograph of Clavaria and allied genera. Beih. Nova Hegwigia. 1970, 33, 1–299. [Google Scholar]
- Bruehl, G.W.; Machtmes, R.; Kiyomoto, R. Taxonomic relationships among Typhula species as revealed by mating experiments. Phytopathology 1975, 65, 1108–1114. [Google Scholar] [CrossRef]
- White, T.J.; Bruns, T.; Lee, S.; Taylor, J. Amplification and direct sequencing of fungal ribosomal RNA genes for phylogenetics. In PCR Protocols: a guide to methods and applications; Academic Press: Cambridge, CA, USA, 1990; pp. 315–322. [Google Scholar]
- Thompson, J.D.; Higgns, D.G.; Gibson, T.J. CLUSTAL W: improving the sensitivity of progressive multiple sequence alignment through sequence weighting, position specific gap penalties and weight matrix choice. Nucl. Acids Res. 1994, 18, 7213–7218. [Google Scholar] [CrossRef]
- Kimura, M. A simple method for estimating evolutionary rates of base substitutions through comparative studies of nucleotide sequences. J. Mol. Evol. 1980, 16, 111–120. [Google Scholar] [CrossRef]
- Saitou, N.; Nei, M. The neighbor-joining method: a new method for reconstructing phylogenetic trees. Mol. Biol. Evol. 1987, 4, 406–425. [Google Scholar]
- Anonymous. Royal Botanic Garden Edinburgh. Flora of British fungi, colour identification chart; Her Majesty’s Stationary Office: Edinburgh, UK, 1969. [Google Scholar]
- Corner, E.J.H. A monograph of Clavaria and allied genera; Oxford University Press: London, UK, 1950. [Google Scholar]
- Kawakami, A.; Matsumoto, N.; Naito, S. Environmental factors influencing sporocarp formation in Typhula ishikariensis. J. Gen. Plant Pathol. 2004, 70, 1–6. [Google Scholar] [CrossRef]
- Tkachenko, O.B. Adaptation of the fungus Typhula ishikariensis Imai to the soil inhabitance (in Russian). Mikol. Fitopato. 1995, 29, 14–19. [Google Scholar]
- Olariagara, T.; Huhtinen, S.; Lassøe, T.; Petersen, J.H.; Hansen, K.; Parra, L.A. Proposals to the names Typhula with a conserved type, Macrotyphula against Sclerotium, and Phyllotopsidaceae against Scleroticeae, and to reject the name Sclerotium fulvum (Basidiomycota: Agaricales). Taxon 2022, 71, 468–470. [Google Scholar] [CrossRef]
- Lind, J. Studies on the geographical distribution of arctic circumpolar Micromycetes. Kgl. Danske Vidensk. Selskab. Biol. Medd. 1934, 1–152. [Google Scholar]
- Hoshino, T.; Asef, M.R.; Fujiwara, M.; Yumoto, I.; Zare, R. One of the southern limits of geographical distribution of sclerotium forming snow mould fungi: First records of Typhula species from Iran. Rostaniha 2007, 8, 35–45. [Google Scholar]
- Bensaude, M. Diseases of economic plants in the Azores. Bull. Misc. Inform. Kew 1926, 6, 381–389. [Google Scholar] [CrossRef]
- Matsumoto, N.; Tronsmo, A.M.; Shimanuki, T. Genetic and biological characteristics of Typhula ishikariensis from Norway. Eur. J. Plant Pathol. 1996, 102, 431–439. [Google Scholar] [CrossRef]
- Matsumoto, N. Evolution and adaptation in snow mold fungi (in Japanese, with English abstract). Soil Microorganisms 1997, 50, 13–19. [Google Scholar]
- Tkachenko, O.B. Snow mold fungi in Russia. In Plant and microbe adaptation to cold in a changing world; Springer: New York, NY, USA, 2013; pp. 293–303. [Google Scholar]
- Elenev, P. Mesures agricoles pour combattre la pourriture hibernale des céréales (in Russian). La Défense des Plantes 1926, 3, 39–42. [Google Scholar]
- Kask, K. Kõrrelist mükoosid, nende reservatsioonikolded ja tõrjevõimalused Eesti NSV-S; Eessti Maaviljeluse ja Maaparanduse Teadusliku Uurimise Instituut: Saku, Estonia, 1966. [Google Scholar]
- Sokirko, G.V.S.; Zazimko, M.I. Fitopatogennye griby (Morfologiya i Sistematika); Kuban State Agrarian University: Krasnodar, Russia, 2014. [Google Scholar]
- Campbell, W.A. A new species of Coniothyrium parasitic on sclerotia. Mycologia 1947, 39, 190–195. [Google Scholar] [CrossRef]
- Dejardin, R.A.; Ward, E.W.B. Growth and respiration of psychrophilic species of the genus Typhula. Can. J. Bot. 1971, 49, 339–347. [Google Scholar] [CrossRef]
- Hoshino, T. Ecophysiology of snow md fungi. Curr. Top. Plant Biol. 2005, 6, 27–35. [Google Scholar]
- Hoshino, T.; Xiao, N.; Yajima, Y.; Tkachenko, O.B. Fungi in cryosphere: their adaptations to environments, In Cold-adapted microorganisms; Yumoto, I., Ed.; Caister Academic Press: Portland, OR, USA, 2013; pp. 51–68. [Google Scholar]
- Favre, J. Les Champignons supérieurs de la zone alpine du Parc national Suisse; Druck Ludin: Liestal, Switzerland, 1955. [Google Scholar]
- Rose, A.H. Physiology of microorganisms at low temperatures. J. Appl. Bacteriol. 1968, 31, 182–184. [Google Scholar] [CrossRef] [PubMed]
- Beales, N. (2006). Adaptation of microorganisms to cold temperatures, weak acid preservatives, low pH, and osmotic stress: a review. Comp. Rev. Food Sci. Food. Safety 2006, 3, 1–20. [Google Scholar] [CrossRef]
- Stakhov, V.L.; Gubin, S.V.; Maksimovich, S.V.; Rebrikov, D.V.; Savilova, A.M.; Kochkina, G.A.; Ozerskaya, S.M.; Ivanushkina, N.E.; and Vorobyva, E.A. Microbial communities of ancient seeds derived from permanently frozen Pleistocene deposits. Mikrobiologia 2008, 77, 348–355. [Google Scholar] [CrossRef]
- Duman, J.A.; Olsen, T.M. Thermal hysteresis protein activity in bacteria, fungi, and phylogenetically diverse plants. Cryobiology 1993, 30, 322–328. [Google Scholar] [CrossRef]
- Arai, T.; Fukami, D.; Hoshino, T.; Kondo, H.; Tsuda, S. Ice-binding proteins from the fungus Antarcomyces psychrotrophicus possibly originated from two different bacteria through horizontal gene transfer. FEBS J. 2018, 286, 946–962. [Google Scholar] [CrossRef]
- Ekstrand, H. Hostsadens och vallgrasens overwintering. Statens Vaxtskyddsanstallt Meddelande 1955, 67, 1–125. [Google Scholar]
- Hoshino, T.; Kiriaki, M.; Tsuda, S.; Ohgiya, S.; Kondo, H.; Yokota, Y.; Yumoto, I. Antifreeze proteins from. basidiomycetes. Patent No. US 7,442,769 B2, 28 October 2008. [Google Scholar]
- Knudsen, H. Mycology in Greenland – an introduction. Medd. on Grønl. Biosci. 2006, 56, 7–16. [Google Scholar]
- Tojo, M.; Nishitani, S. The effects of the smut fungus Microbotryum bistotarum on survival and growth of Polygonum vivparum in Svalbard. Can. J. Bot. 2005, 83, 1513–1517. [Google Scholar] [CrossRef]
- Tomiyama, K. Studies of the snow blight disease of winter cereals (in Japanese, English abstract). Hokkaido Natl. Agric. Exp. Stn. Rep. 1955, 47, 1–234. [Google Scholar]
- Bruehl, G.W.; Cunfer, B.M. Physiologic and environmental factors that affect the severity of snow mold of wheat. Phytopathology 1971, 61, 792–799. [Google Scholar] [CrossRef]
- Namikawa, Y.; Watanabe, T.; Saito, I.; Takasawa, T. Growth of the psychrophilic snow mold Sclerotinia borealis on the agar under xerophilic conditions (in Japanese with English abstract). Res. Bull. Obihiro Univ. 2004, 25, 23–26. [Google Scholar]
- Hoshino, T.; Terami, F.; Tkachenko, O.B.; Tojo, M.; Matsumoto, N. Mycelial growth of the snow mold fungus, Sclerotinia borealis improved at low water potentials: an adaptation to frozen environment. Mycoscience 2010, 51, 98–102. [Google Scholar] [CrossRef]

Disclaimer/Publisher’s Note: The statements, opinions and data contained in all publications are solely those of the individual author(s) and contributor(s) and not of MDPI and/or the editor(s). MDPI and/or the editor(s) disclaim responsibility for any injury to people or property resulting from any ideas, methods, instructions or products referred to in the content. |
© 2023 by the authors. Licensee MDPI, Basel, Switzerland. This article is an open access article distributed under the terms and conditions of the Creative Commons Attribution (CC BY) license (http://creativecommons.org/licenses/by/4.0/).
